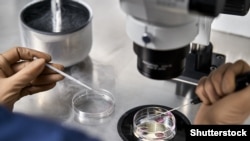
Një tekniku duke kontrolluar mbarëvajtjen e procesit të fekondimit in vitro në një laborator për IVF. Fotografi ilustruese.

“Po të mos kishte klinikë private, unë nuk do ta kisha atë”, thotë Krisztina Kazinczy, duke folur për djalin e saj të vogël nga një kënd lojërash në periferi të Budapestit.
Djali i saj, tani gati dy vjeç, ka lindur pasi prindërit e tij i janë nënshtruar trajtimit të njohur si fertilizim in vitro - IVF - në një klinikë private.
Por, rrëfimet e tilla në Hungari mund të jenë tani gjithnjë e më të rralla, pasi nga 30 qershori, Qeveria i ka nxjerrë jashtë ligjit të gjitha institucionet private që ofrojnë trajtim IVF.
Kryeministri i krahut të djathtë, Viktor Orban, e ka justifikuar këtë veprim, duke thënë se është ndërmarrë për ta bërë procedurën më të qasshme dhe për të ndihmuar në ndalimin e tkurrjes së popullsisë hungareze.
Popullsia e këtij vendi është pothuajse në rënie të vazhdueshme nga viti 1980 dhe është nën 10 milionë nga viti 2010.
Numri i lindjeve është në rritje nga viti 2019, por edhe numri i vdekjeve po ashtu, sidomos pas shpërthimit të pandemisë së koronavirusit.
Ndalimi i IVF-it në klinika private ka reduktuar në mënyrë drastike mundësitë për shumë gra dhe çifte që kanë probleme me shtatzëninë.
Pas kësaj ndalese, ato i kanë dy mundësi: të provojnë fatin në spitalet shtetërore, me lista të gjata pritjeje, ose të kërkojnë trajtime më të shtrenjta jashtë vendit.
Kazinczy, 38 vjeçe, konsulente e pavarur, thotë se ka bërë disa runde të IVF-it në një spital shtetëror, përpara se të zgjidhte të shkonte në klinikë private.
“Nuk do ta harroj kurrë kur na thirrën pesë prej nesh [grave] dhe na thanë të zhvishemi. Kur mjeku mbaroi me personin e parë, i dyti hyri menjëherë. Ndërkohë, ne qëndronim lakuriq pranë njëra-tjetrës, sepse nuk kishin kohë të mjaftueshme për të pritur që ne të zhvisheshim dhe të visheshim”, thotë Kazinczy.
Përvoja e saj në sektorin privat thotë se ishte krejtësisht ndryshe.
Ajo tregon se nuk ka pasur nevojë ta shpjegojë historinë e saj mjekësore në çdo takim dhe thotë se mjekët kanë qenë të informuar mirë për rastin e saj.
Pas dy rundesh trajtimi në klinikë private, Kazinczy ka mbetur shtatzënë.
Foshnja e parë hungareze me IVF ka lindur në maj të vitit 1989 në qytetin jugperëndimor të Hungarisë, Pecs.
Një vit më vonë, Steven Kaali, një mjek me origjinë hungareze, me bazë në SHBA, ka vendosur të hapë një klinikë fertiliteti në Budapest.
Qendra, e cila është hapur në vitin 1992 në një nga lagjet më të pasura të Budapestit, është bërë shpejt e njohur në Hungari dhe jashtë saj.
Deri në vitin 2017, Instituti Kaali - i quajtur sipas babait të Kaalit, gjinekolog - ka ndihmuar në lindjen e mbi 25,000 fëmijëve. Kjo, sipas një letre që Kaali i ka shkruar kryeministrit Orban. Letra është botuar në një biografi të Kaalit, e cila përfshin edhe një fotografi të nënshkruar të mjekut dhe udhëheqësit veteran të Hungarisë, partia e të cilit, Fidesz, ka fituar sërish zgjedhjet në prill.
Të tetë qendrat e Institutit Kaali në Hungari janë blerë nga Qeveria në vitin 2019 për një shumë që nuk është zbuluar.
Arsyeja e shitjes nuk është bërë kurrë publike. Në dhjetor të vitit 2019, ministri i Burimeve Njerëzore, Miklos Kasler, ka thënë se mbi dhjetë miliardë forinta (24.5 milionë dollarë) do të shpenzohen në klinika për IVF, si dhe në trajtime dhe mjekime tjera që mbështesin fertilitetin.
Në maj të vitit 2021, Qeveria hungareze ka marrë vendim për ndalimin e fertilitetit në klinika private, nisur nga 30 qershori i vitit 2022.
Shteti ka blerë një klinikë tjetër private me bazë në Budapest - qendrën Robert Karoly - dhe dy qendra private të fertilitetit në kryeqytet, Versys Clinics dhe Reprosys Fertility Center, të cilat janë mbyllur, duke mos pasur mundësi të ofrojnë shërbime sipas ligjit të ri.
Radio Evropa e Lirë i ka kontaktuar të tria institucionet për koment, por nuk ka marrë përgjigje.
Për njerëzit që kërkojnë trajtim të fertilitetit në Hungari, mbyllja e shërbimeve private është një goditje e madhe.
Anita, 41 vjeçe, e cila preferon të identifikohet vetëm me emër, jeton në Szentendre - një qytet afër Budapestit. Ajo ka dy djem adoleshentë dhe do të donte të kishte një fëmijë me burrin e saj të ri. Ka mbetur shtatzënë dy herë vitin e fundit, por të dyja herët ka dështuar.
Tani, Anita nuk ka zgjidhje tjetër, veçse të shkojë në një spital shtetëror. Trajtimi është kryesisht falas, por bashkëshortit të Anitës i është dashur të bëjë edhe disa ekzaminime privat.
“Kur thirra asistentin e mjekut në shtator, më tha se vendi i parë në dispozicion është në janar. Por, nëse paguajmë, mund të shkojmë në tetor”, tregon Anita për ekzaminimet private të bashkëshortit.
Anita po përgatitet për rundin e dytë dhe të fundit të IVF-së në sistemin shtetëror, por ka dyshime nëse i ka kryer ekzaminimet e duhura përpara procedurës.
“I kërkova mjekut së paku të pëshpëriste emrin e ekzaminimeve [shtesë] që mund t’i bëjmë dhe do t’i bënim në ndonjë [klinikë] private, por ai nuk ma tha”, thotë Anita.
“Sikur të kisha mundësi, do të shkoja në Çeki”, thotë ajo.
Disa hungarezë edhe mund ta përballojnë të shkojnë jashtë vendit.
Sipas Gabriela Nemethovas, koordinatore e IVF-së në klinikën Gyncare në Nitra - qytet në Sllovakinë perëndimore - numri i pacientëve hungarezë “është shumëfishuar” viteve të fundit. Në klinikën sllovake, një konsultë bazë është 50 euro, ndërsa një rund i plotë i IVF-së kushton 1.200 euro.
Nemethova flet hungarisht dhe është punësuar në mënyrë që klinika të mund t’u ofrojë shërbime klientëve hungarezë.
Të dyja klinikat sllovake të Gyncare kanë koordinatorë që flasin gjuhën hungareze dhe kanë infermierë, recepsionistë dhe mjekë që mund të flasin hungarisht, ose së paku anglisht.
“Ne kemi disa pacientë që nuk donin të prisnin radhën e tyre në Hungari”, thotë Nemethova.
“Por, ka të tjerë që nuk mund të trajtohen në këto institucione, për shembull për shkak të moshës së tyre. Ka edhe nga ata që mund ta përballojnë, por nuk mund të marrin trajtimin që duan”, shton ajo.
Për personat e komunitetit LGBT, sfidat janë edhe më të mëdha.
Laura, një gjermane me grua hungareze, e ndan kohën e saj mes Budapestit dhe kryeqytetit të Austrisë, Vjenës.
Tani, në muajin e tetë të shtatzënisë, ajo thotë se për të dhe gruan e saj, Zsuzsanna, Hungaria nuk ka qenë kurrë opsion, pasi IVF-ja atje është e disponueshme vetëm për çiftet hetero-normative, ose për gratë beqare që i afrohen fundit të viteve të riprodhimit.
Pasi Republika Çeke dhe Sllovakia kanë kufizime të ngjashme për çiftet e gjinisë së njëjtë, Laura, e cila preferon të përdorë vetëm emrin e saj, ka nisur procedurën e IVF-së në Vjenë.
Mangësitë në sektorin shëndetësor shtetëror të Hungarisë shkojnë përtej qendrave të fertilitetit.
Për shkak të asaj që kritikët e shohin si mungesë fondesh, spitalet hungareze shpesh përballen me mungesa pajisjesh dhe stafi. Sipas një vlerësimi, sektori i kujdesit shëndetësor i Hungarisë ka një mungesë prej 25.000 punonjësish mjekësorë, e cila pritet të përkeqësohet me kalimin e kohës, pasi më pak të rinj zgjedhin këtë fushë.
Një spital në Szolok - qytet me 71.000 banorë - ka njoftuar së voni se mund të asistojë lindje vetëm të hënave dhe të mërkurave, ndërsa reparti i maternitetit i një spitali tjetër rural është mbyllur, për shkak të mungesës së mjekëve.
Barbola, 30 vjeçe, nënë e një foshnje 5-javëshe, thotë se iu nënshtrua IVF-së në një spital shtetëror në Budapest.
“Ata janë atje për të na bërë fëmijë, edhe nëse kjo nuk tingëllon aq bukur. Pavarësisht kësaj, të gjithë kanë qenë të mirë dhe të ndjeshëm”, thotë ajo.
“Nuk dyshoj në kthimin tim atje. U ndjeva e sigurt”, shton Barbola.
Pavarësisht përvojës së saj pozitive në sektorin shtetëror, ajo është e shqetësuar për vendimin e Qeverisë për klinikat private.
“Kam frikë se [institucionet shtetërore] do të mbingarkohen, saqë do të ketë mijëra procedura të pasuksesshme. Ne ishim me fat, kemi marrë trajtim në mes të kryeqytetit. Problemet reale janë në zonat rurale”, thotë ajo.
Për ata që shpresojnë të bëhen prindër, pasiguria e shtuar në një proces stresues është rraskapitëse. Shumë ish-pacientë privatë janë mërzitur që vezët e tyre ruhen në një klinikë që tani financohet nga shteti.
Disa kanë arritur të bëjnë transferime - në minutën e fundit - në klinika jashtë vendit, ose në institucione të tjera shtetërore.

Facebook Forum